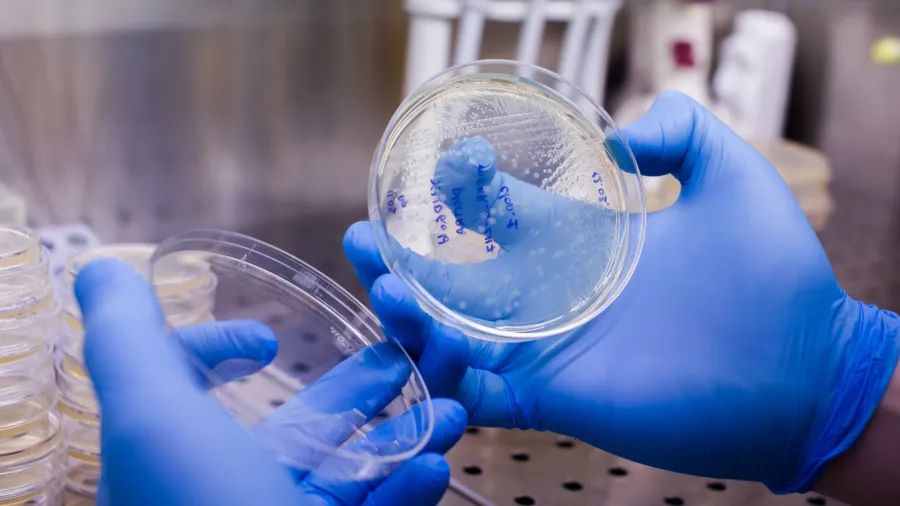

Diffuse large B-cell lymphoma therapeutics market to be valued $2.24b by 2028
The market is driven by advancements, such as CAR-T cell therapy and monoclonal antibodies.
The global market for diffuse large B-cell lymphoma (DLBCL) therapeutics is projected to grow by $2.24b until 2028 at an estimated compound annual growth rate (CAGR) of 8.09%.
A report by Technavio revealed that the market is experiencing notable growth due to an increasing number of diagnosed cases and the development of new treatment options amidst a growing geriatric population.
In line with this, the market is set to witness a trend towards technological advancements with the development of CAR-T cell therapy gaining popularity due to longer remission periods and improved patient outcomes.
“Additionally, monoclonal antibodies like Ibrutinib and Idelalisib are making a mark in the market with their ability to target specific proteins in DLBCL cells,” The report said.
However, the market is impacted by the high costs involved in advanced therapies potentially impeding its growth.
Furthermore, it is challenged by issues such as treatment-associated drug resistance and potential side effects that can affect patient compliance.
“The market requires innovative solutions to improve treatment efficacy, reduce costs, and enhance patient experience,” the report added.